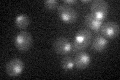
YMR223W
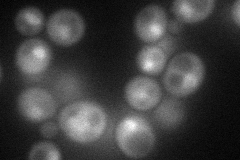
YMR223W
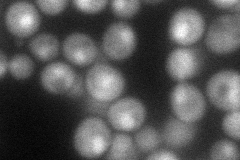
YMR223W
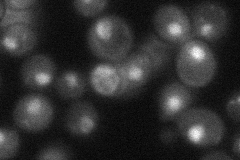
YMR223W
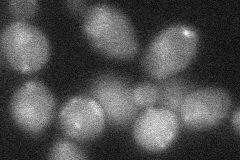
YMR223W

View description
Ubiquitin-specific protease that is a component of the SAGA (Spt-Ada-Gcn5-Acetyltransferase) acetylation complex; required for SAGA-mediated deubiquitination of histone H2B
Localization:
Intensity:
Fold change:
Significance:
-
C’ GFP library in SD
nucleus25.29 -
N' NOP1pr-GFP in SD
cytosol,nucleus61.8672 -
N' TEF2pr-mCherry in SD
nucleus60.2443 -
N' NATIVEpr-GFP in SD
nucleus33.6566 -
N' TEF2pr-VC and Cyto-VN in SD
below threshold26.9004 -
C’ GFP library in SD+DTT

nucleus22.880.9No -
C’ GFP library in SD+H2O2

nucleus22.430.88No -
C’ GFP library in Starvation Media

nucleus25.521No -
C’ GFP library on the background of Pup2-DaMP

nucleus -
C’ GFP library on the background of CCT mutant

nucleus21.58610.853001No
